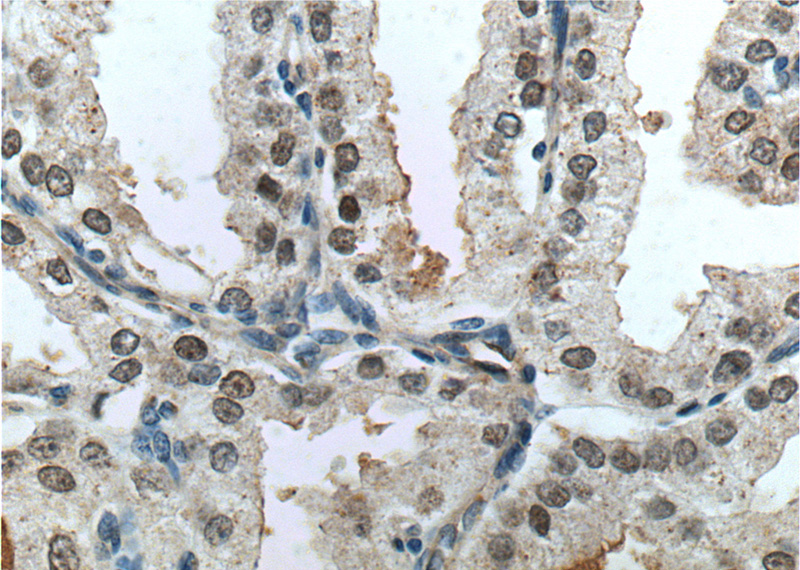
Immunohistochemistry of paraffin-embedded human prostate cancer tissue slide using Catalog No:110745(FOXA1 Antibody) at dilution of 1:200 (under 40x lens). heat mediated antigen retrieved with Tris-EDTA buffer(pH9).

-
Product Name
FOXA1 antibody
- Documents
-
Description
FOXA1 Rabbit Polyclonal antibody. Positive WB detected in MCF7 cells, HepG2 cells, PC-3 cells. Positive IHC detected in human prostate cancer tissue. Observed molecular weight by Western-blot: 50 kDa
-
Tested applications
ELISA, WB, IHC
-
Species reactivity
Human, Mouse; other species not tested.
-
Alternative names
forkhead box A1 antibody; Forkhead box protein A1 antibody; FOXA1 antibody; HNF 3 alpha antibody; HNF 3A antibody; HNF3A antibody; TCF 3A antibody; TCF3A antibody; Transcription factor 3A antibody
-
Isotype
Rabbit IgG
-
Preparation
This antibody was obtained by immunization of FOXA1 recombinant protein (Accession Number: NM_004496). Purification method: Antigen affinity purified.
-
Clonality
Polyclonal
-
Formulation
PBS with 0.02% sodium azide and 50% glycerol pH 7.3.
-
Storage instructions
Store at -20℃. DO NOT ALIQUOT
-
Applications
Recommended Dilution:
WB: 1:200-1:2000
IHC: 1:20-1:200
-
Validations

MCF7 cells were subjected to SDS PAGE followed by western blot with Catalog No:110745(FOXA1 antibody) at dilution of 1:200

Immunohistochemistry of paraffin-embedded human prostate cancer tissue slide using Catalog No:110745(FOXA1 Antibody) at dilution of 1:200 (under 40x lens). heat mediated antigen retrieved with Tris-EDTA buffer(pH9).
Immunohistochemistry of paraffin-embedded human prostate cancer tissue slide using Catalog No:110745(FOXA1 Antibody) at dilution of 1:200 (under 40x lens). heat mediated antigen retrieved with Tris-EDTA buffer(pH9).
-
Background
Forkhead box A1(FOXA1),also named hepatocyte nuclear factor 3-alpha (HNF-3A), is a transcription factor that is involved in embryonic development, establishment of tissue-specific gene expression and regulation of gene expression in differentiated tissues. Is thought to act as a 'pioneer' factor opening the compacted chromatin for other proteins through interactions with nucleosomal core histones and thereby replacing linker histones at target enhancer and/or promoter sites. Binds DNA with the consensus sequence 5'-[AC]A[AT]T[AG]TT[GT][AG][CT]T[CT]-3' (By similarity). Proposed to play a role in translating the epigenetic signatures into cell type-specific enhancer-driven transcriptional programs. Its differential recruitment to chromatin is dependent on distribution of histone H3 methylated at 'Lys-5' (H3K4me2) in estrogen-regulated genes. Involved in the development of multiple endoderm-derived organ systems such as liver, pancreas, lung and prostate; FOXA1 and FOXA2 seem to have at least in part redundant roles (By similarity). Modulates the transcriptional activity of nuclear hormone receptors. Is involved in ESR1-mediated transcription; required for ESR1 binding to the NKX2-1 promoter in breast cancer cells; binds to the RPRM promter and is required for the estrogen-induced repression of RPRM. Involved in regulation of apoptosis by inhibiting the expression of BCL2. Involved in cell cycle regulation by activating expression of CDKN1B, alone or in conjunction with BRCA1. Originally discribed as a transcription activator for a number of liver genes such as AFP, albumin, tyrosine aminotransferase, PEPCK, etc. Interacts with the cis-acting regulatory regions of these genes. Involved in glucose homeostasis.
Related Products / Services
Please note: All products are "FOR RESEARCH USE ONLY AND ARE NOT INTENDED FOR DIAGNOSTIC OR THERAPEUTIC USE"
